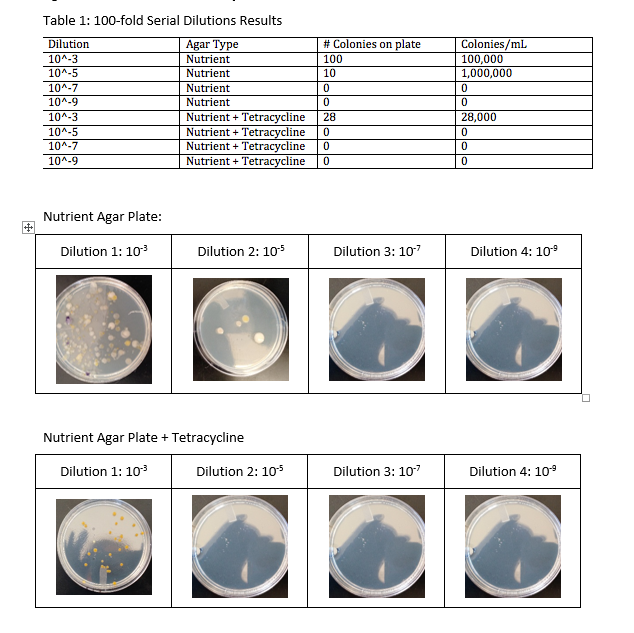

User:Katherine E Hyder/Notebook/Biology 210 at AU
Identifying Bacteria Species through PCR and Sequencing Analysis 3/3/2016
Purpose, Materials and Methods:
In order to more accurately identify the bacterial populations within transect one, DNA from the two bacteria colonies previously studied was isolated and amplified using PCR techniques. Afterwards, the DNA was run through a gel using electrophoresis. No meaningful data was gathered from the gel due to unknown sources of error. Past studies of transect one were able to yield successful data, however, and the results of their PCR and gel electrophoresis were sent to a lab for sequencing. The resulting sequences were then run through a computer program to determine the closest match. It is predicted that the sequences obtained from the results of the PCR and gel electrophoresis will yield different sequences for each colony that can be matched using a computer program to determine the specific species of bacteria present in transect 1.
Results:
DNA Sequence from White Bacteria Colony on Nutrient Plates
The sequence shown above most closely matched Pseudomonas fluorescens.
DNA Sequence from White Bacteria Colony on Tetracycline Plates
The sequence shown above most closely matched Ralstonia pickettii.
Conclusion: Although it is possible that both of these species of bacteria inhabit transect one, it is impossible to know for sure. Populations within ecosystems are constantly adapting, evolving and changing. So much time has passed between now and when these previous species were identified, it is seemingly unlikely that they are the exact same species that inhabits the transect now as new generations of bacteria are formed multiple times per hour. It seems highly doubtful that these populations could have not changed significantly over the course of so many thousands of generations.
Zebrafish Experiment Day 1, 2, 5 and 7 2/18/16
Purpose: In order to determine the effect of epinephrine alone, metaprol alone and the combination of metapropal and epinephrine on zebrafish development, zebrafish eggs were placed in one of these three treatments and allowed to develop. In order to compare their growth to that of typically developing zebrafish, a fourth control group was placed into deer park water. If either metapropal or epinephrine affect zebrafish development, then the mixture treatment group will either display the same effects as those receiving the individual treatments or some sort of combination of their effects. Because epinephrine and metapropal have opposite functions when used to treat certain human conditions (vasoconstrictor vs. vasodilator), it is also possible that any effects displayed by each of the individual treatments, will cancel each other out due to the opposite nature of the function of the two substances studied. Studying the effects of these medications is important as they can potentially be applied to hypothesize their effects on human development when a fetus is exposed in vitro.
Materials and Methods:
On day one, 2/18/16, four 24 well-plates were labeled for each of the treatment groups. A single zebrafish egg was then placed in each of the treatment wells. 2 ml of the plates’ respective treatments was placed in each well. After the treatments were set, the embryos were staged using a dissection microscope. The plates were then covered and allowed to sit undisturbed on a tray in the lab.
On day two, 2/19/16, a second iteration of the experiment was begun due to the high number of non-surviving eggs on each of the treatment plates from the first iterations. It was hypothesized, however, that the low survival rate was not attributed to the treatments but rather the overall health of the embryos used due to similar survival rates across all four plates. The plates were then set aside and used to compare with the second iteration.
This time, each of four petri dishes was set up with 20 healthy embryos, and 25 ml of treatment was added to each of the dishes. The embryos were again examined under a dissection microscope to determine their starting developmental stage.
On day five, 2/22/16, the eggs in the well plates were examined under the dissection microscope. A count was taken of the dead, living and hatched eggs. Selected individuals from each plate were measured and staged. Observations of their movement patterns were also recorded.
On day seven, 2/24/16, the eggs in the well plates and the eggs in the petri dishes were examined under the dissection microscope. The same data was collected for each plate and dish.
Data and Observations
Table 2: Size and Movement Data
Conclusions
At this point in time, it appears as though there are few differences between the control and treated fish. The fish within petri dishes appear to be healthier than their counterparts on the plates. The fish receiving metapropol treatments (both the mix and metapropol) seem slightly less healthy. The decision was made to discontinue the data collection for the fish in the well plates.
'Characterizing Invertebrates and Potential Vertebrates from Transect 1'2/11/2016
Purpose:
The invertebrates and vertebrates present in an ecosystem play an important role in the functioning of that ecosystem. Invertebrates and vertebrates are incredibly diverse and have unique traits which can be used to help identify them. In order to better observe and describe the different organisms and populations and their interactions with both each other and the environment samples of invertebrates were collected, observed and classified according to their observed characteristics. Additionally, speculations of the types of vertebrates were hypothesized, and evidence was gathered to support the likelihood of their presence in the transect. It is hypothesized that a diverse range of invertebrate species will be found in the transect 1 sample. Likely they will belong to the Arthopoda phylum.
Materials and Methods:
A Berlese funnel was filled with leaf litter from the transect and placed over a tube filled with ethanol to collect invertebrates which fell through the funnel. The Berlese funnel was allowed to sit for one week in a covered area. After incubating for one week, the Berlese funnel was dissembled and the solution in the tube containing the collected invertebrates were split equally between two a petri dishes.
Observations of each plate were made using a dissection microscope. A paper based and online dichotomous key was used to identify five of the organisms found in the sample. The size, types of organisms found and their identifying features were recorded.
Using evidence collected from the observations of transect 1, speculations were made about the different types of vertebrates which could realistically inhabit the transect. In order to identify the specific species of vertebrates likely to be present, research was done online to determine the predominant bird and rodent species found in the area surrounding transect 1.
Data and Observations''
Table 1: Organisms Observed from Berlese Funnel
Vertebrates
<Based on the known ecology of transect, five vertebrate species were hypothesized to be its potential inhabitants. The table below lists the different species and the biotic and abiotic factors which could support their presence in the transect, and were used as evidence to support their identification as some of its potential inhabitants.
Table 3: Potential Vertebrates in transect 1
This food web shows the basic patterns of interactions within the community of organisms inhabiting transect 1. At the first trophic level, primary producers, predominately plants and photosynthetic bacteria, convert sunlight and CO2 into carbon-based energy compounds. At the second trophic level protists and invertebrates consume the primary producers. Vertebrates such as the Rice Rat, American Gray Squirrel and Deer Mouse also feed on the plant life, especially the acorns produced by the tree. At the third trophic level, vertebrates such as the American Robin and American Tree Sparrow along arachnids feed on invertebrates such as Annelida and Diplopoda. Finally, after an organism of any tropic level dies, it is decomposed by bacteria and fungi. The fungi and bacteria are then consumed by other bacteria and invertebrates for energy. Essentially, all of the varying levels are closely connected and dependent on one another. This connectedness, however, is essential to the survival of the ecosystem. Because resources within the ecosystem are limited, this interconnected web of predators and prey sustains a balance within the ecosystem, ensuring that many species are able to cohabit t the same time.
Conclusion:
Overall, a diverse range of invertebrates were collected from the transect and were able to be classified according to each specimen’s unique characteristics. As hypothesized, all of the organisms found belonged to the Phylum Arthopoda. Yet they varied with regards to size, shape, order and class. The arthropods ranged from 1 to 12 mm with the smallest being Arachnida acarina and the largest Diploda. The most common arthropod was of the class Arachnida, though it is possible that this was due to their increased visibility with regards to their size. Potentially, other invertebrates occur more frequently throughout the transect, they are just too small to detect with the dissection microscope alone. Perhaps, taking samples of the liquid to prepare slides for observation under the compound light microscope would yield different frequency data. Additionally, leaf litter from only a very small section of the transect was used. Perhaps different samples from different areas within the transect would also yield different results.
Characterizing Monocot and Dicot Plants From Transect 1 by Identifying Their Vascularization 2/4/2016
Purpose:
Within an ecosystem the plant populations within it play an important role within the system itself. The characteristics of the plants within the transect can give important clues as to how the ecosystem has changed over time and the adaptations which makes different plants better able to survive. These characteristics include vascularity, classification as a monocot or dicot and the presence and type of specialized structures. In order to better understand the unique characteristics and its different populations' interactions, plant samples from transect 1 were observed and classified according to the characteristics listed above. Because there are many niches to fill within an ecosystem, it is expected that both monocots and dicots will be present in the transect.
Materials and Methods: Samples of six plants were removed from the transect and taken to the lab. Their source location was noted and efforts were made to preserve the roots of the samples as this vascularization would be important for identifying and characterizing each plant. Each plants' vascularization, measurement and vein structure were recorded and used to classify the plants.
Cross sections of each plant were then taken with a standard razor blade and then placed on a depression slide and viewed under the microscope.
Because there were no seeds in the transect as samples were collected during the winter when few plants germinate seeds, no observations or cross sections of seed were made. Furthermore, no flowers and/or ferns were located in the transect, thus they also could not be examined at the time of the experiment. Therefore no observations or cross sections of seeds were possible. Standard fungi samples prepared in lab by the teaching assistant and were examined using the dissecting microscope and described.
To prepare for an upcoming experiment, 25mL of 50:50 ethanol/water was placed into a 50 mL conical tube. Screening material was placed over the bottom of a Berlese funnel and filled with leaf litter. The entire structure was then placed under a lighted 40 watt lamp and covered with foil to incubate for the next seven days.
Results
Table 1: Plant Sample Chracteristics
Table 2: Plant Descriptions and Classifications
Fungi
Fungi sporangia are the structures used by fungi during reproduction. Meiosis occurs and the spores occur in the sporangium. Once meiosis occurs the spores are released into the environment and scattered by means of water, wind and animals. Spores are very hardy and able to endure dry enviornments until there is enough moisture to support their growth.
Three fungi samples were examined under the microscope. One of the samples belonged to the Basidimycota group. These fungi are known as mushrooms and characterized by their stem and cap-like structures which emerge above ground. Another sample contained the common bread mold which is considered a Zygomycete. These types of fungi are characterized by their spore releasing structures. The final sample was identified as Ascomycota based upon the appearance of its mycelium and the black, speck-like sac structures. (Freeman, 2013)
The picture of the Ascomycota fungi sample is shown below. Its mass of hyphae filaments form a mycelium, which indicate that it is a fungus. The black speck-like sacs are most likely the ascocarps used for reproduction
Conclusions:
Evidence from the samples collected indicates that the predominate part of the plant populations in transect 1 are vascular and include a mix of different kinds of monocots and dicots. Because the wintertime is characterized as a time of limited plant growth and reproduction, performing the same experiment in the spring may yield more diverse results and change the overall characterization of the plant life found in the transect.
Source:
Freeman, Scott. K, Quillin, L, Allison. (2013).
KH
Identifying Bacteria Cultures from Transect 1 1/28/2016
Purpose:
Bacteria and Archaea species within an ecosystem have an essential role within the overall functioning of that ecosystems. The types and characteristics of the Bacteria and Archaea species present within the ecosystem can give clues as to the evolution of that ecosystem over time and the nature of the environment. A variety of methods can be used to identify these species and their characteristics including PCR and DNA sequencing as well as observation and Gram-staining techniques. Because Transect 1 is not an environment characterized as extreme, it is unlikely that any Archaea species will be present. It is expected, however, that a variety of different bacteria species will be observable on the agar plate cultures made using transect 1’s hay infusion. If there are any antibiotic-resistant bacteria within the ecosystem, the plates containing the antibiotic will still contain bacteria. If there are differences within the structures of their cell walls a gram stain will be able to be used to determine which colonies have cell walls that contain peptidoglycan and which do not.
Materials and Methods:
- After one week of growth, the agar plate cultures containing samples from the transect were observed and the observable bacteria colonies on each plate were counted and described.
- Samples from two colonies on the 10 nutrient only colonies and two of the nutrient tetracycline samples were taken and used to create wet mount slides for observation.
- A loop was sterilized using a flame and was then used to take samples from two different bacterial colonies on each of the 10-3 dilution agar plates, one with tetracycline and one without tetracycline. It was sterilized using the same procedure between each sampling.
- Each sample was mixed with a drop of distilled water on a glass microscope slide and covered with a standard cover slip.
- The samples were then observed with the 10X and 40X objectives of a standard compound light microscope and visible differences regarding their size, shape and color were noted.
- Samples from the same colonies were then taken and a gram stain was completed to determine the composition of their cell walls.
Data and Results:
Hay Infusion Culture Updates:
Previously, the hay infusion from transect 1 had no detectable smell. Currently, it smells like musty and moldy. There is some evidence of water line recession due to evaporation as some of the sediment from the transect was found on the sides of the jar above the water line. The water itself appears darker/ murkier in color. The suspended sediment continues to support the life of some sort of colony-based microorganisms. The colony appears to have increased in size and number. The colonies originally present on the water’s surface no longer are observable.
The changes in the smell of the infusion can likely be attributed to the differences in bacteria, fungi and protists currently inhabiting the infusion. Because the environment is constantly changing, different species and populations became extinct and/or became better able to survive. Each of these different organisms emits a slightly different odor, and depending on their concentration throughout the sample, produce a collectively different smell. Additionally, overtime, decomposition of the various plants and dead organisms occurs. Decomposition has varying smells as it progresses because the decomposing organisms produce different smell and waste products at different times.
Because Transect 1 is not an environment characterized as extreme, it is unlikely that any Archaea species will be present. It is expected, however, that a variety of different bacteria species will be observable on the agar plate cultures made using transect 1's hay infusion.
Agar Plate Observations: Colony Numbers and Visible Characteristics
There were more observably diverse bacteria colonies found on the 10-3 nutrient only plate had than the 10-3 nutrient tetracycline plate. The colonies found on the nutrient plate were purple, white, white-clear, yellow and orange in color, and, on average larger than those found on the nutrient tetracycline plate. Overall, this sizing trend remained true between the nutrient vs. nutrient tetracycline plates for the other dilutions as well. The colonies on the 10-3 nutrient tetracycline plate included several small, orange colonies and one small, pale yellow colony. The orange colony on this plate looked very similar to one of the orange colonies found on the nutrient only plate.
As expected, the more dilute the sample used to inoculate the plate, the fewer colonies that were found upon it for both the nutrient only and nutrient tetracycline plates. None of the plates had observable bacteria growth beyond those receiving the 10-5 dilution, and the nutrient tetracycline plate at this dilution did not have any observable qualities either. On the nutrient only plate of this dilution, only ten colonies were observed. (Please note, only 4 are visible in the picture above). These colonies appeared to be similar to the yellow, white and white-clear colonies observed on the original 10-3 nutrient only plate.
Conclusions:
Based on the results of the experiment, it seems as though tetracycline limits the diversity and amount of the bacteria populations able to grow and reproduce. Primarily, it appears as though the presence of peptidoglycan determines the bacteria population’s chance of survival. Only bacteria colonies which were gram-negative were observed on the nutrient tetracycline plate. Although the two colonies tested from the nutrient only plate were both gram-positive, it appears likely that some of the colonies on the plate would test as gram-negative as well since they appear to resemble some of the ones found on the nutrient tetracycline plate. This could only be determined by taking samples from the un-tested colonies and performing the same gram stain.
These experimental results suggest that the presence of peptidoglycan could potentially play a role in a population's resistance to tetracycline. Yet, according to Marilyn Roberts of University of Washington, tetracycline targets a broad range of bacteria, including those that are gram-positive and gram negative. Thus, the resistance must be attributed to another factor. Likely, the resistance comes from mutations in their genetic sequence which change the cell's permeability. (Roberts, 2003).
To further extend the experiment, the DNA from samples of each of these colonies should be analyzed for the presence of these mutations.
Sources:
Roberts, M. C. (2003). Tetracycline Therapy: Update. Clinical Infectious Diseases CLIN INFECT DIS, 36(4), 462-467.
KH
Protists and Algae Transect #1 1/21/2016
Hay Infusion Culture Observations
The water in the culture appears to be clear with a murky, green tint throughout the sample. On the jar just above the water line, a green/brown algae growth has formed. The water seems to have a murky gray/brown film floating on the top of the sample. The film appears to be comprised of some sort of colonial organism. Most of the sticks and sediment from the culture settled down at the bottom of the jar where a clear, colonial organism forming alongside of them. A few blades of grass and pieces of sediment are suspended midway in the water and are supporting the growth of some sort of brown, hair-like organisms. No distinct smell was noted to be coming from the infusion culture.
Organism Relationships with Plant Matter Speculations
Perhaps the organisms that live closer to the plants rely on the plants for energy and/or oxygen to survive. Because plants are producers they can provide energy to heterotrophs which must consume their source of energy. Other autotrophs, however, may want to live further away from the plant matter to reduce competition.
Protists and Algae Present in Hay Infusion Culture
Fulfilling the Needs of Life:
In order to survive, every organism needs to be comprised of at least one cell and able to procure energy, store information, replicate and evolve. (Freeman, 2014). The Paramecium multimicron in this ecosystem meets each of these criteria. As a heterotroph, it obtains energy by consuming other organisms such as bacteria and algae. It is comprised of a single cell and contains the genetic information necessary for reproduction. It reproduces via binary fission resulting in two identical organisms. During cell division mistakes can be made during the DNA replication process and often result in mutations of the genetic code. Although some of these mutations are "silent," others can lead to substantial phenotypic differences between parent and offspring. Because paramecium are subject to such mutations, they are able to sustain genetic variability, better equipping them to survive. Yet, they are also able to interact with their environment and often adapt to the conditions present. Those who are able to adapt survive longer and their offspring have better chances to survive and reproduce themselves. These adaptations eventually lead to evolution through natural selection. (http://www.fcps.edu/islandcreekes/ecology/paramecium.htm).
Hay Infusion Future Growth Predictions
If the infusion were to continue to grow over the next several months, then it is likely that many of these organisms would adapt, change and find different niches. If competition for resources became too intense many of the different organisms may die out. Because water evaporates over time, and many of these organisms depend upon water to survive, it is likely that only a few of the original organism species would remain present throughout the entire incubation.
Serial Dilution Procedure
KH
Transect 1 Description 1/11/2016
Aerial Map and Google Earth View
https://www.google.com/maps/@38.9370164,-77.087324,375a,20y,90h/data=!3m1!1e3
Biotic and Abiotic Components
|
Biotic |
Abiotic |
|
Clover-like plants |
Twigs, leaves and sticks on the ground |
|
Grasses |
Acorns (non-sprouted) |
|
Small bush-like trees |
Soils |
|
Large trees |
Bark |
|
Large growth on tree—potentially some sort of fungus |
Lamp |
|
Squirrel (as evidenced by a half-eaten acorn) |
Sprinklers |
|
Plant/tree roots |
Rocks |
|
Acorns (sprouted) |
Sidewalk |
Competitive and Symbiotic Relationships
|
Competitive |
Symbiotic |
|
Squirrel eating the acorns prevents some of them from growing |
Squirrel eating the acorns/gathering them helps spread them further away from the parent tree and more likely to grow and mature |
|
Plants and trees must compete for space, nutrients from the soil and water |
Fungi/bacteria in soil decompose dead, non-living matter turning it into nutrient-rich soil to nourish the plants |
General Description
Transect Number 1 is a 20ft by 20ft section of American University's campus located near the sidewalk on the Ward Circle Building side between the Hurst Hall's Northern Side and the Ward Circle Building's Southern Side. This transect contains ten trees: 2 larger oak trees and 8 smaller, bush-like trees. It has several large grassy patches on the eastern side which borders the sidewalk and many smaller patches of grass dispersed throughout the area. There are also small patches of clover-like plants spread throughout the transect. The soil is dark and contains many acorns, twigs, sticks and leaves. Some of the acorns are sprouted and some are not. One of the acorns appears to be half-eaten, suggesting that perhaps a squirrel or some other sort of seed-eating animal frequents the area. There are rocks dispersed throughout the area as well as one lamppost and several sprinklers.
-KH